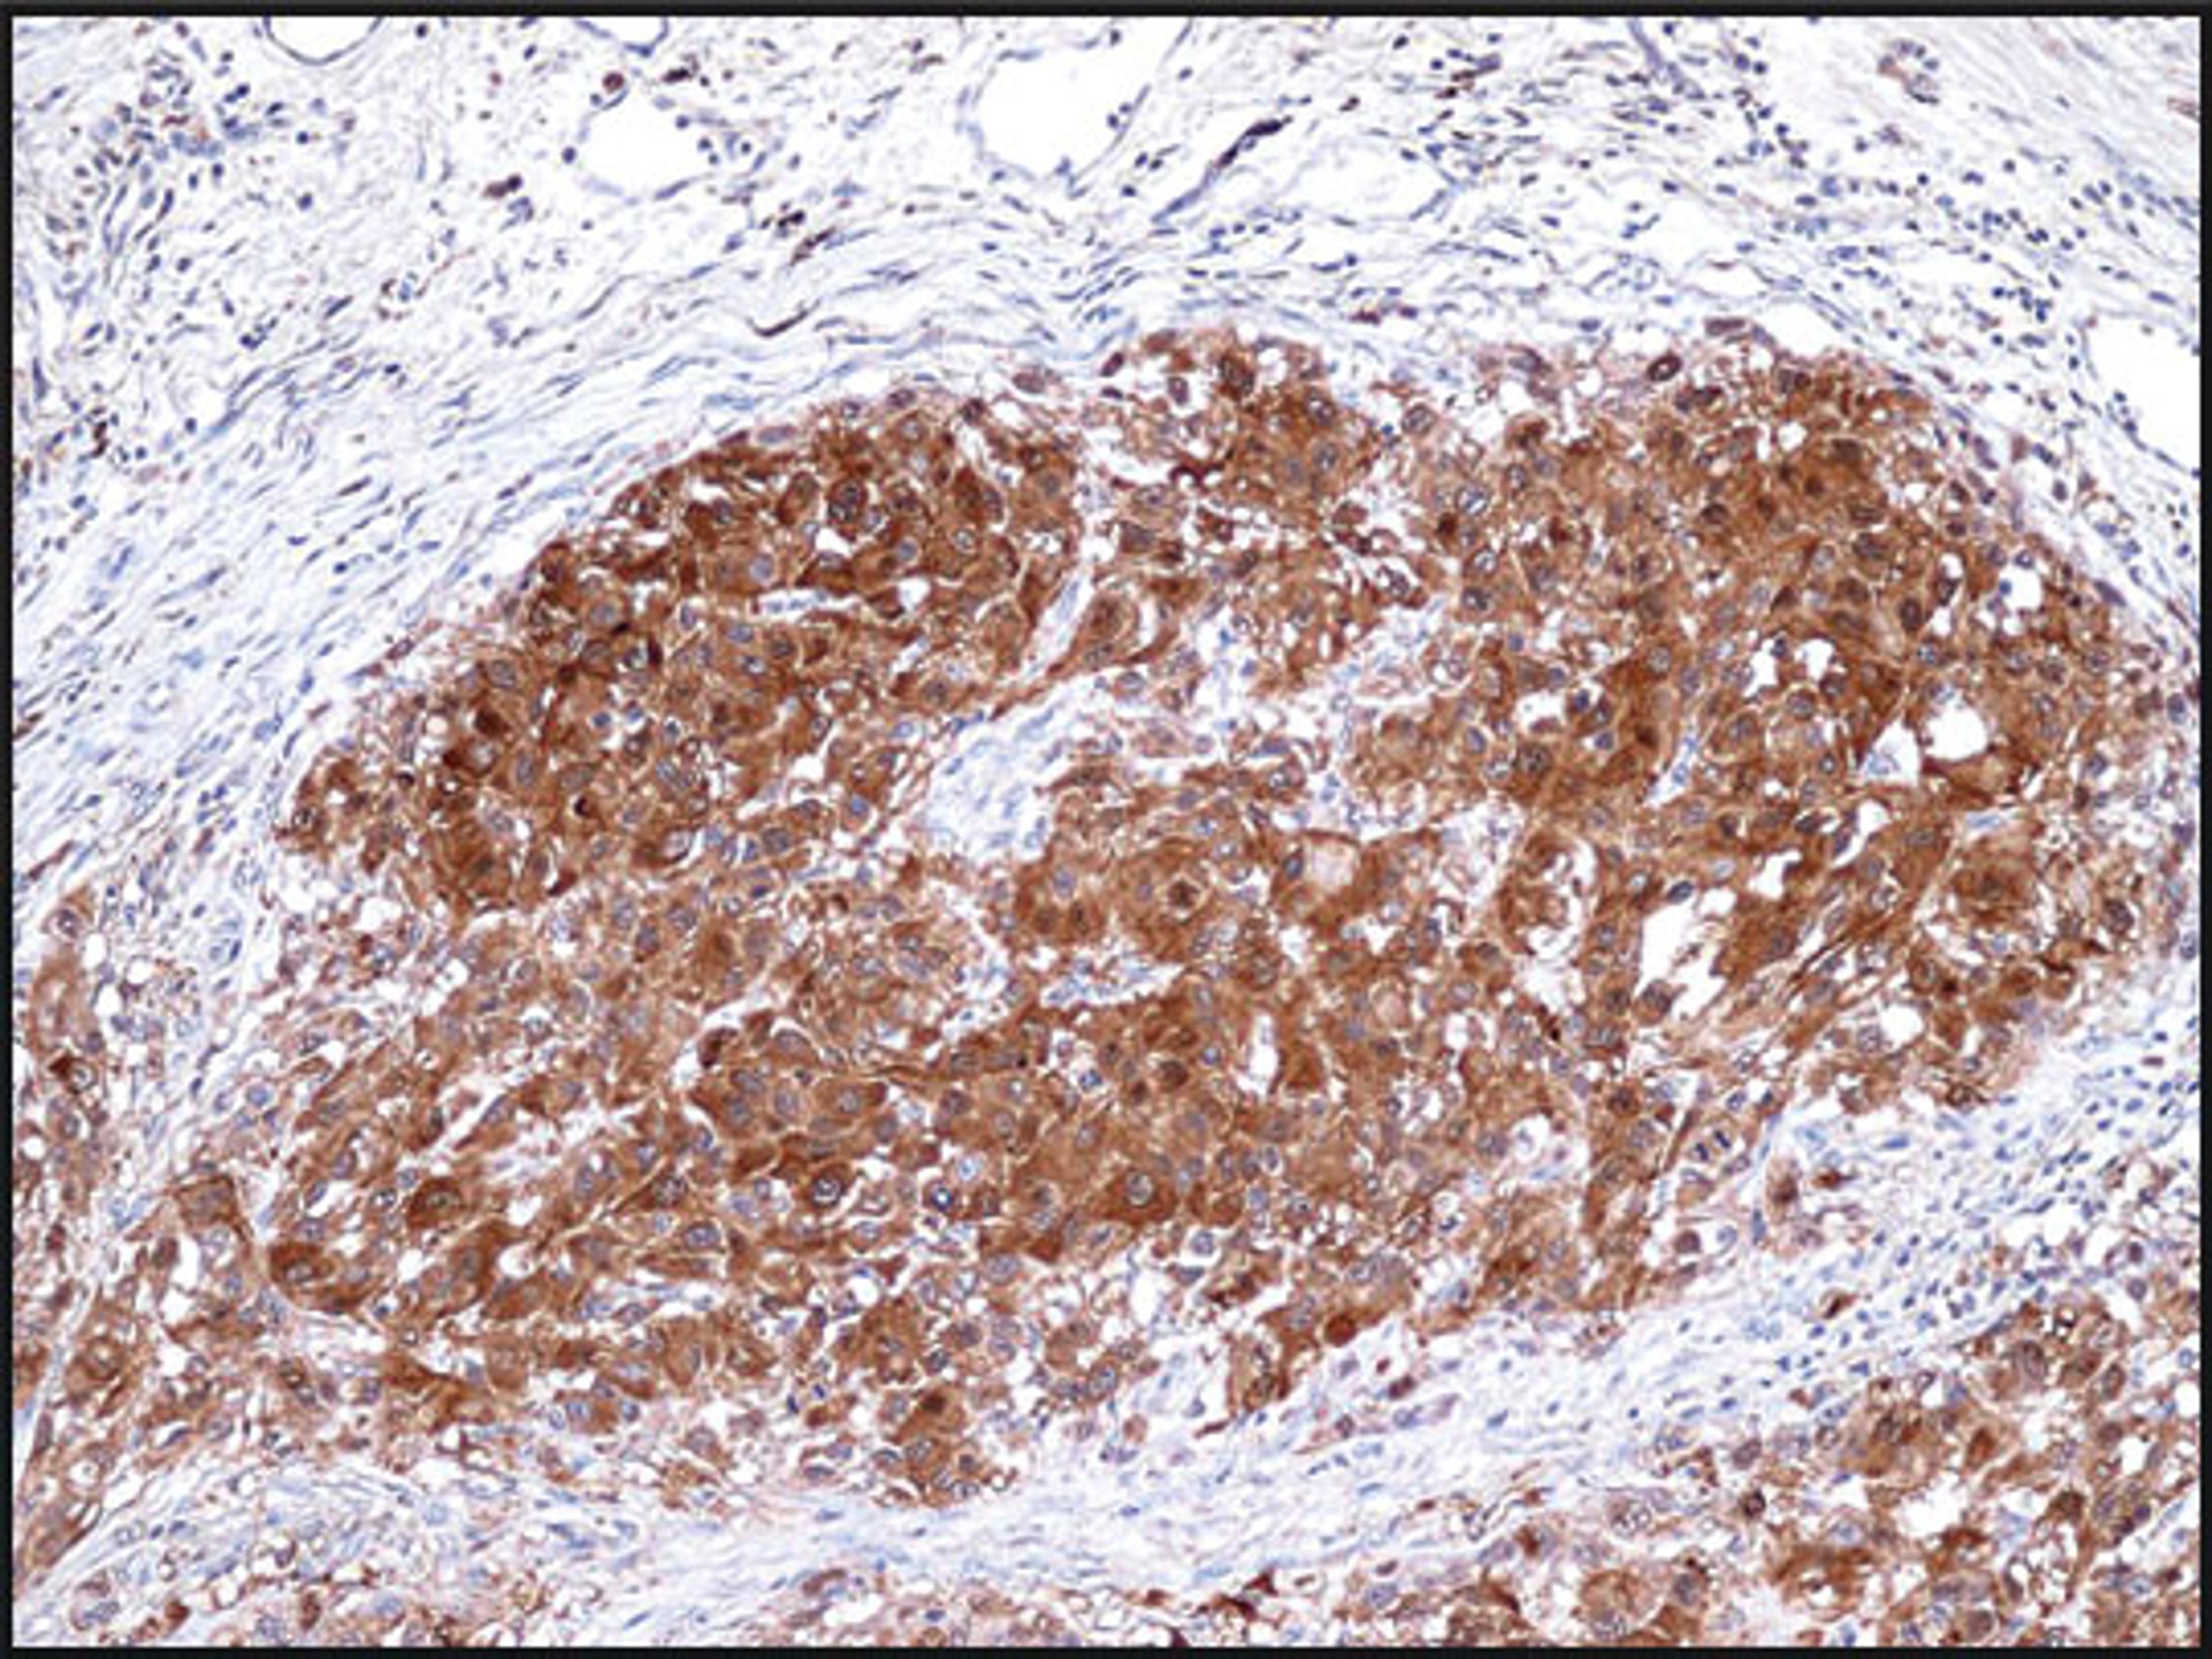
Immunohistochemistry staining of S100A4 in human breast tissue (4 microns) tissue using S100A4 Antibody.

Product & ReviewsAntibodies
S100A4 Antibody
Product Details
- Cat. No.
- 51-091
- Type
- Primary Antibody
- Clonality
- Polyclonal
- Host
- Rabbit

The supplier does not provide quotations for this antibody through SelectScience. You can search for similar antibodies in our Antibody Directory.
Biological Information
- Clonality: Polyclonal
- Host: Rabbit
- Antigen: S100A1
- Source: Purified
- Gene: 6271
Handling
- Quantity: 0.1 mL
- Storage: Store at +4 °C. DO NOT FREEZE.
- Buffer: 20 mM Tris-HCl, pH 8.0, 20 mg/mL BSA, 0.05% sodium azide